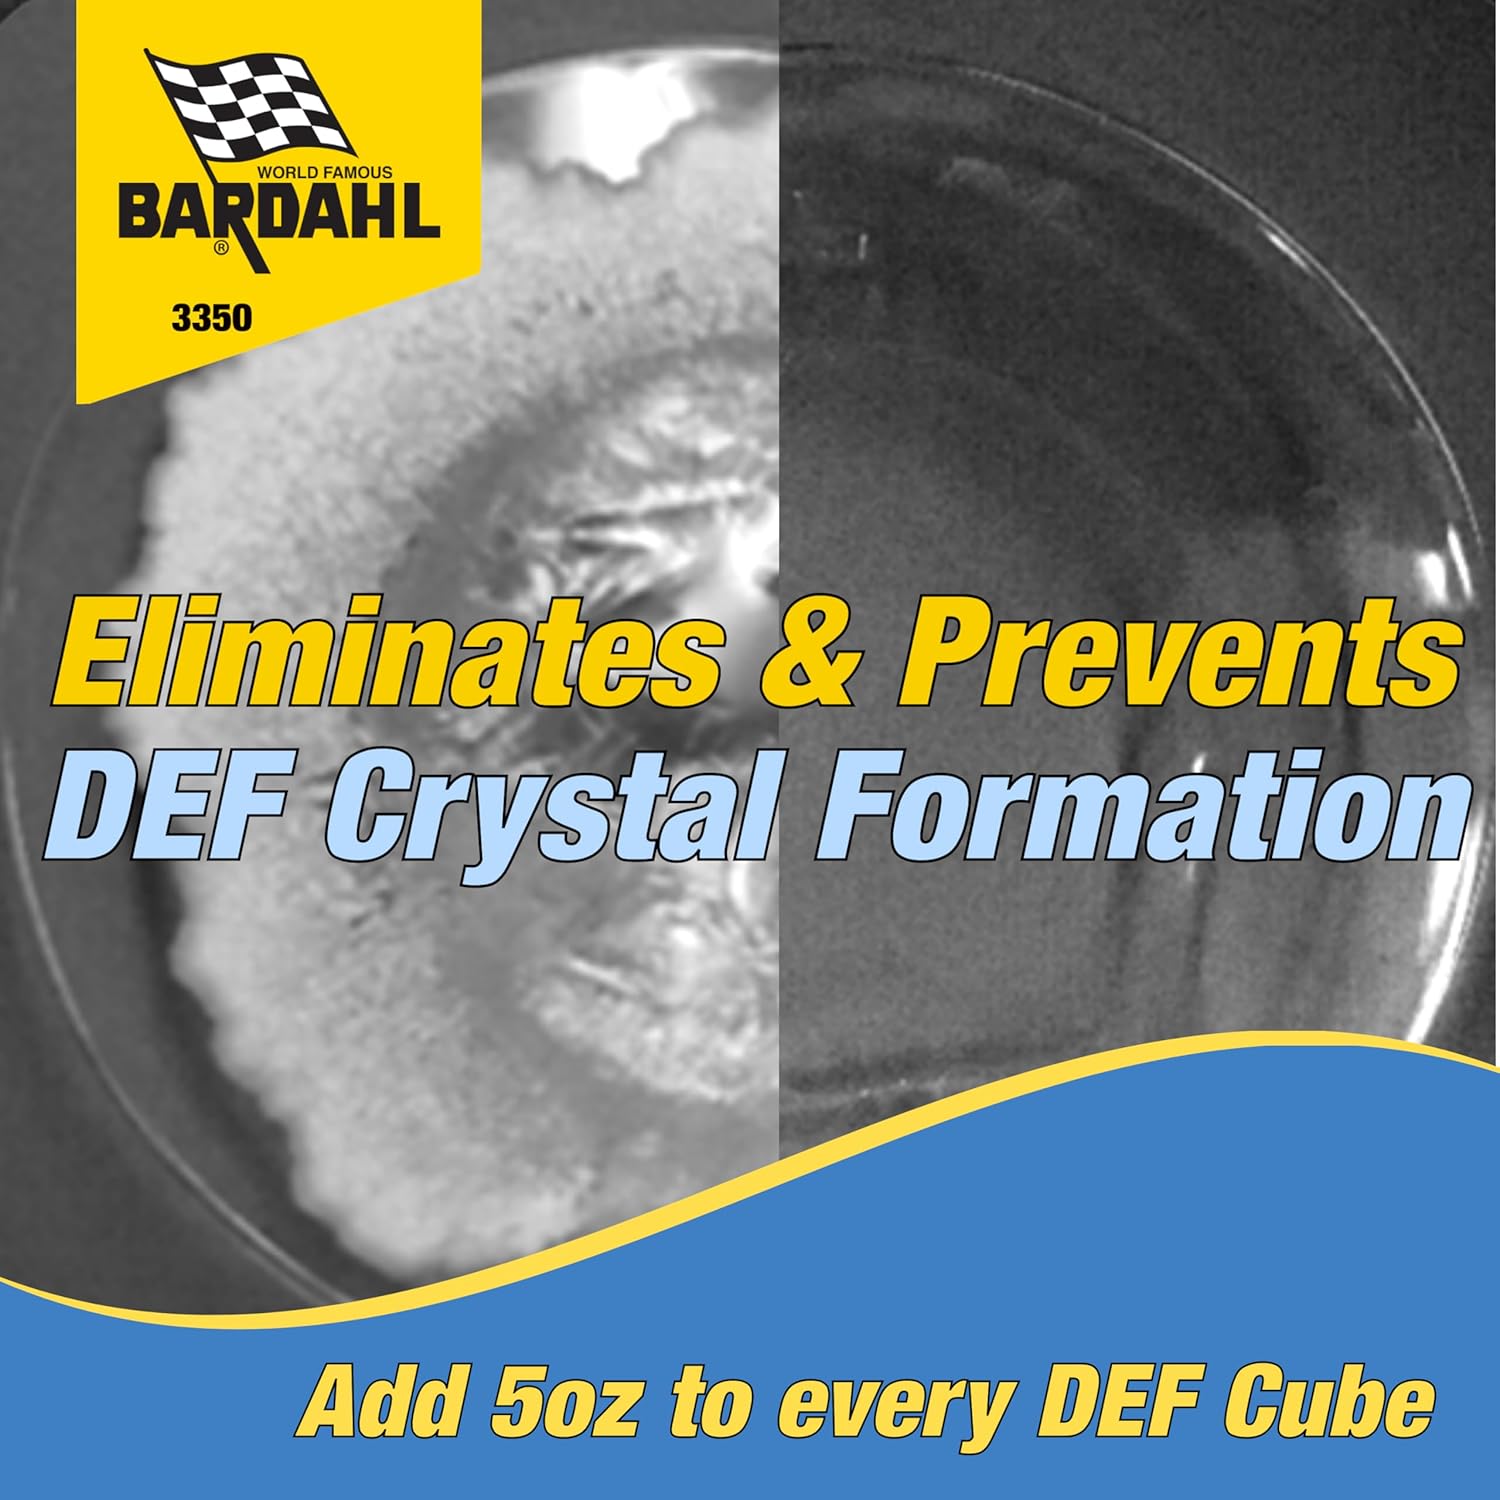

Descrição do Produto: 3350 – Tratamento para Motores a Diesel
O 3350 é um tratamento inovador para motores a diesel, projetado para otimizar o desempenho e a eficiência do seu veículo. Com uma fórmula avançada, este produto se destaca pela sua capacidade de REMOVER DEPOSITOS EFETIVAMENTE. Ele elimina os resíduos deixados pelo fluido de escape de diesel (DEF), garantindo um sistema de escape limpo e proporcionando lubrificação adicional ao motor. Essa ação não apenas melhora o desempenho do motor, mas também oferece um cuidado diário que potencializa a performance do seu veículo.
Além disso, o 3350 promove uma MELHORIA NO DESEMPENHO DOS INJETORES. Ao restaurar os padrões ideais de spray do DEF, o produto reduz o consumo e aumenta a eficiência, protegendo componentes essenciais como o tanque, bomba, aquecedor, transmissor, linhas, injetor e misturador. Essa proteção é crucial para a longevidade do sistema de injeção e para a manutenção da eficiência do motor.
Outro benefício significativo do 3350 é o AUMENTO DO PODER DO MOTOR. O tratamento reduz a contrapressão, resultando em um aumento da potência do motor, melhor economia de combustível e maior quilometragem. Ao limpar não apenas o sistema de emissões e escape, mas também o sistema de combustível, o 3350 contribui para uma redução no consumo de combustível, tornando-se uma escolha inteligente para motoristas que buscam eficiência.
A MANUTENÇÃO FÁCIL é um dos grandes diferenciais do 3350. O tratamento diário previne reparos dispendiosos ao manter o sistema DEF limpo. A melhor maneira de evitar uma quebra cara é prevenir que ela aconteça, e o 3350 é a solução ideal para isso.
- Instruções de Uso:
Para utilizar o 3350, adicione uma garrafa ao cubo/jarra de DEF antes de abastecer. Uma garrafa trata 2,5 galões (9,46 L) de DEF. É importante descartar qualquer solução usada ou não utilizada de acordo com as regulamentações locais, estaduais e federais.
Características do Produto:
– Capacidade de Tratamento: Cada garrafa trata até 2,5 galões (9,46 L) de DEF.
– Composição: Fórmula avançada que elimina depósitos e melhora a lubrificação do motor.
– Compatibilidade: Seguro para uso em todos os sistemas de injeção de diesel.
– Fácil Aplicação: Simples adição ao sistema DEF, sem necessidade de ferramentas especiais.
– Prevenção de Danos: Reduz a necessidade de reparos dispendiosos ao manter o sistema limpo.
Perguntas Frequentes (FAQ):
Pergunta: O 3350 é seguro para todos os motores a diesel?
Resposta: Sim, o 3350 é formulado para ser seguro e eficaz em todos os sistemas de injeção de diesel.
Pergunta: Com que frequência devo usar o 3350?
Resposta: Recomendamos o uso do 3350 a cada abastecimento para garantir a máxima eficiência e proteção do motor.
Pergunta: O que devo fazer se eu usar mais do que a quantidade recomendada?
Resposta: Se você usar mais do que a quantidade recomendada, não se preocupe. O produto é seguro, mas é sempre melhor seguir as instruções para obter os melhores resultados.
Pergunta: O 3350 pode ajudar a melhorar a economia de combustível?
Resposta: Sim, ao limpar o sistema de combustível e reduzir a contrapressão, o 3350 pode ajudar a melhorar a economia de combustível.
Pergunta: Como devo descartar o produto usado?
Resposta: O descarte deve ser feito de acordo com as regulamentações locais, estaduais e federais. Consulte as diretrizes de descarte de produtos químicos em sua área.
 Frete Grátis em todos os produtos
Frete Grátis em todos os produtos

Avaliações
Não há avaliações ainda.